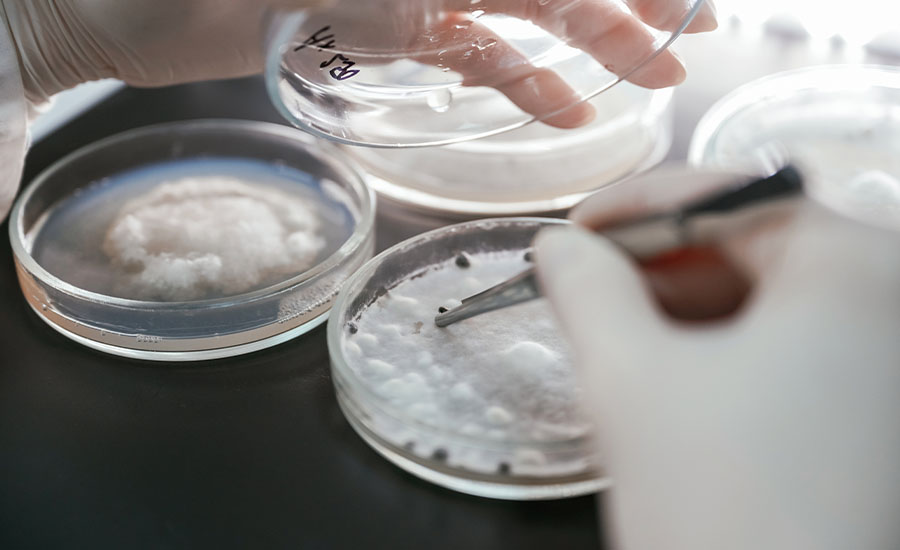

Stringent
Quality Control
We implement rigorous quality control measures throughout our production process, ensuring that every batch of salt meets the highest standards of purity and consistency. Our dedicated quality assurance team conducts thorough inspections and tests, identifying and rectifying any deviations to maintain the superior quality that our customers expect and trust from Yug Enterprise.
Advanced
Testing Facilities
Our state-of-the-art facilities employ cutting-edge technology to ensure our salt meets the highest standards. These methods verify product consistency and purity, reinforcing our commitment to excellence in every batch.

Continuous
Improvement
We embrace innovation and feedback to enhance our processes and product quality. By integrating new technologies, we adapt to market demands while maintaining our high standards of excellence and efficiency.

Customer
Satisfaction Focus
We strive to exceed customer expectations with superior products and responsive service. Our customer-centric approach builds strong, long-term relationships, making us a trusted partner in the salt industry.
Compliance and
Safety Standards
Yug Enterprise adheres to strict compliance and safety standards to ensure the integrity of our products and the safety of our operations. We comply with all relevant industry regulations and environmental guidelines, minimizing our impact on the environment. Our robust safety protocols protect both our workforce and the communities we serve.

